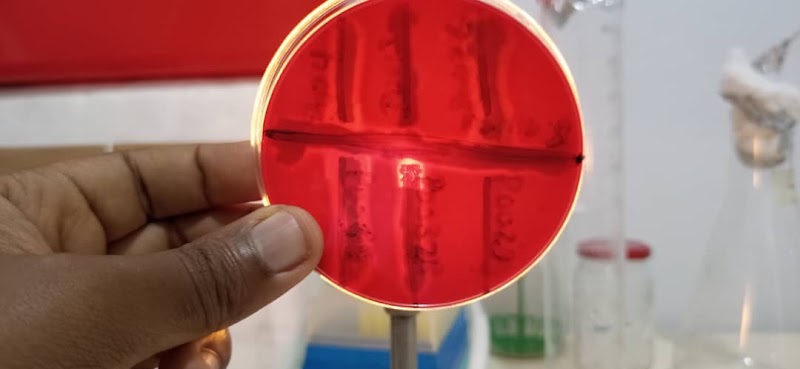
AU_ZVEEW32YZZYpU6c0iKA4KS1YsmRnZvxfI0mVe0ESjTKPdbxDTgQmdXgAkJchricg6qio9gGBwsB2icwzGvPLygx8-6T4tkhrOqFd0qq7Rl6az18iqfOu6Tb8TYrvKgoLkIhsGVNpSqBF9DFd79O1bLva310fqgxO1yduRJaZ9RQrPSCGzs5Ke64tLu_HhRUJ1Gz8HHJkaa8PiJOVB-BKrvoa4-J41q5Y1jVsYCV_BZctwCP-0IS1fyAFgbFsMNIdmlUbkVLHjLJ26JYRTRjANe4ut0c6LWV-LZZ32ic8ZRJcNuw_1

Carte et informations d'accès
Yaoundé
Yaoundé , CM
Présentation
Photos
 Google Maps
Google Maps  Google Maps
Google Maps  Google Maps
Google Maps Google Maps
Google Maps  Google Maps
Google Maps Horaires d'ouverture
OPERATIONAL
- Monday: Open 24 hours
- Tuesday: Open 24 hours
- Wednesday: Open 24 hours
- Thursday: Open 24 hours
- Friday: Open 24 hours
- Saturday: Open 24 hours
- Sunday: Open 24 hours

